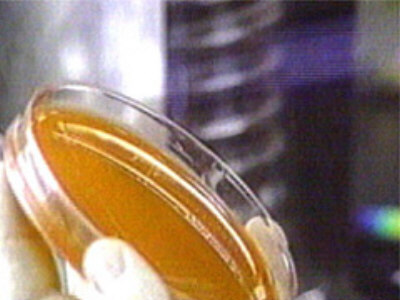
24oktmiltbrandPakistan400.jpg (32823 bytes)

Den biologiske terrorisme er
nået til Pakistan. To tilfælde af miltbrand er allerede i fredags blevet opdaget i byen
Karachi i den sydlige del af landet, oplyser anonyme kilder fra universitetshospitalet i
Karachi til et engelsksproget dagblad i Islamabad. Det nationale sundhedsinstitut i
Pakistan bekræfter oplysningen overfor Radioavisen.
Ligesom i USA er den livsfarlige bakterie sendt
med posten. Miltbrandsporerne blev sendt til en amerikansk ejet bank og et firma, der
handler med amerikanske computerprodukter. Begge breve er afsendt fra USA.
Miltbrandbakterien er nu fundet i Pakistan. Til gengæld viser nye undersøgesler som
disse, at der alligevel ikke var miltbrand i et brev til Kenya.
Det ene af de to breve var fyldt med miltbrandsporer blandet med pulver, mens det andet
brev kun indeholdt meget små mængder bakteriesporer. Personalet i de to firmaer er under
behandling, oplyser kilder ved universitetshospitalet.
Myndighederne tavse
Et medlem af hospitalets ledelse, der også ønsker at være anonym, oplyser, at
hospitalet allerede har sendt en detaljeret rapport til regeringen i Islamabad.
Hospitalet opfordrer til at igangsætte en oplysningskampagne, så befolkningen kan tage
sine forholdsregler og udvise forsigtighed. Miltbrand kan kureres, hvis det opdages i
tide.
De officielle pakistanske myndigheder er usædvanligt tavse om sagen. Ifølge endnu en
anonym kilde i det pakistanske sundhedsministerium, overvejer militærregeringen, hvilken
strategi den skal tage i anvendelse overfor offentligheden.
Alligevel ikke miltbrand i Kenya
Til gengæld siger den amerikanske ambassade i Kenya, at det brev til en kenyansk
forretningsmand, hvor der i sidste uge blev fundet miltbrandbakterier, alligevel ikke
indeholdt bakterien. Det meddelte landets sundhedsministerium ellers i torsdags.
- Vi betragter nu prøven som negativ for miltbrand, siger en talsmand for ambassaden til
nyhedsbureauet AFP, efter nye analyser har givet negativt resultat.
Samtidig har de fundne spor af miltbrand på et brev i Argentina vist sig at være af en
sjælden art, der ikke er smittefarlig for mennesker.
De Argentinske sundhedsmyndigheder vil dog fortsat foretage en sammenligning mellem det
argentinske fund og de fundne stammer af miltbrand i breve i USA.
Kilde: Reuters/ CNN
|